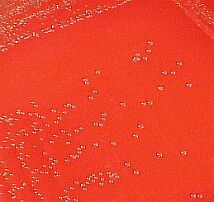

| Curso de Enfermedades Infecciosas Porcinas / Crecimiento GalerÌa Fotogr·fica - Estreptococias |
| Crecimiento de Streptococcus suis en medio de cultivo sólido suplementado con sangre de cordero. La hemólisis es tan débil que no se aprecia en la imagen. |